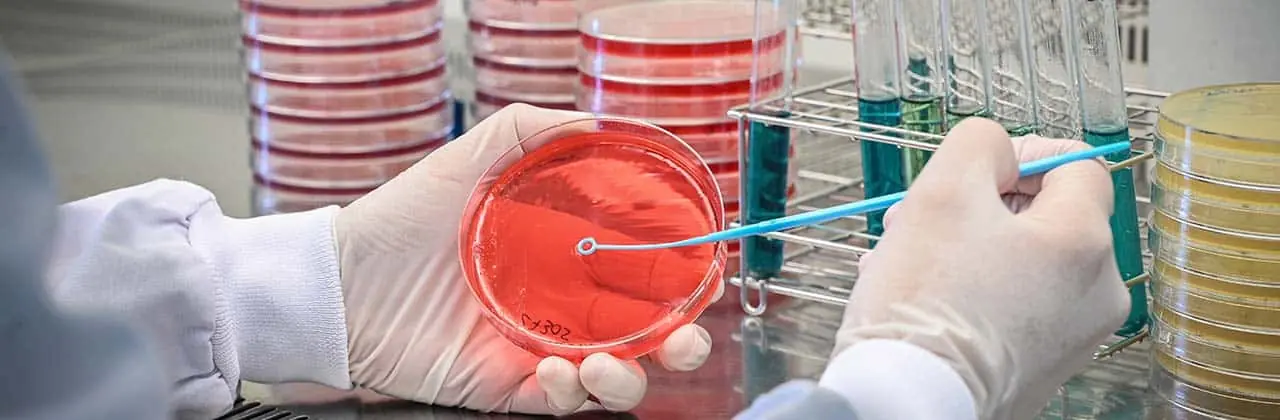

Suscríbete a nuestra newsletter
Objetivo
El objetivo general de VBNC-PATHOGENS es diseñar, desarrollar y validar un conjunto innovador y robusto de metodologías avanzadas que permitan la detección precisa y temprana de patógenos alimentarios en estado fisiológico viable pero no cultivable (VBNC) directamente a partir de matrices alimentarias con el propósito de minimizar su incorporación en la cadena alimentaria. Este proyecto busca no sólo superar las limitaciones de los métodos tradicionales de cultivo, incapaces de identificar este estado bacteriano, sino también establecer un marco científico y tecnológico de referencia que integre el conocimiento actual sobre los mecanismos de inducción y reactivación del estado VBNC, la aplicación de técnicas moleculares y metodologías avanzadas, y la validación de los métodos desarrollados frente a normas ISO.
Actividades
Difusión/Transferencia:
| Responsable | AINIA |
| Domicilio | Calle Benjamín Franklin, 5 a 11, CP 46980 Paterna (Valencia) |
| Finalidad | Atender, registrar y contactarle para resolver la solicitud que nos realice mediante este formulario de contacto |
| Legitimación | Sus datos serán tratados solo con su consentimiento, al marcar la casilla mostrada en este formulario |
| Destinatarios | Sus datos no serán cedidos a terceros |
| Derechos | Tiene derecho a solicitarnos acceder a sus datos, corregirlos o eliminarlos, también puede solicitarnos limitar su tratamiento, oponerse a ello y a la portabilidad de sus datos, dirigiéndose a nuestra dirección postal o a [email protected] |
| Más info | Dispone de más información en nuestra Política de Privacidad |
| DPD | Si tiene dudas sobre como trataremos sus datos o quiere trasladar alguna sugerencia o queja, contacte al Delegado de protección de datos en [email protected] o en el Formulario de atención al interesado |
Consiento el uso de mis datos personales para que atiendan mi solicitud, según lo establecido en su Política de Privacidad.
Consiento el uso de mis datos para recibir información y publicidad de su entidad.